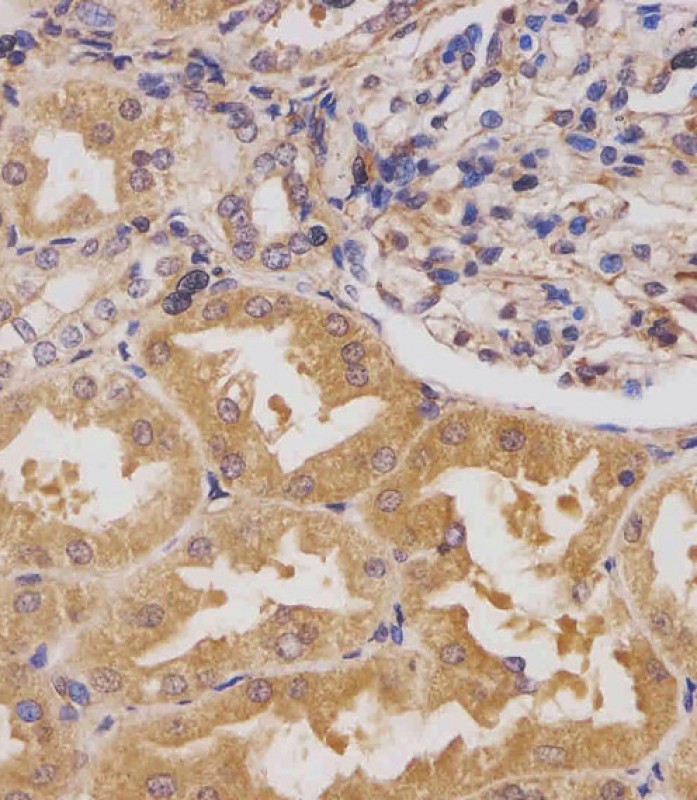

-
分类: 科研抗体货号: P34355别名: HEAT repeat-containing protein 6, Amplified in breast cancer protein 1, HEATR6, ABC1应用: WB反应种属: Human, Rat
-
分类: 科研抗体货号: P34343别名: Synaptojanin-2-binding protein, Mitochondrial outer membrane protein 25, SYNJ2BP, OMP25应用: WB反应种属: Human, Mouse, Rat
-
分类: 科研抗体货号: P34354别名: 3-oxo-5-alpha-steroid 4-dehydrogenase 1, 1.3.1.22, SR type 1, Steroid 5-alpha-reductase 1, S5AR 1, SRD5A1应用: WB反应种属: Human, Mouse, Rat
-
分类: 科研抗体货号: P34342别名: Probable 28S rRNA (cytosine(4447)-C(5))-methyltransferase, 2.1.1.-, Nucleolar protein 1, Nucleolar protein 2 homolog, Proliferating-cell nucleolar antigen p120, Proliferation-associated nucleolar protein p120, NOP2, NOL1, NSUN1应用: WB反应种属: Human, Mouse
-
分类: 科研抗体货号: P34352别名: E3 ubiquitin-protein ligase synoviolin, 632-, Synovial apoptosis inhibitor 1, SYVN1, HRD1, KIAA1810应用: WB,IHC,IF反应种属: Human, Mouse
-
分类: 科研抗体货号: P34370别名: Homeodomain-interacting protein kinase 3, Androgen receptor-interacting nuclear protein kinase, ANPK, Fas-interacting serine/threonine-protein kinase, FIST, Homolog of protein kinase YAK1, HIPK3, DYRK6, FIST3, PKY应用: WB,IHC反应种属: Human, Mouse, Rat
-
分类: 科研抗体货号: P34350别名: Natural resistance-associated macrophage protein 2, NRAMP 2, Divalent cation transporter 1, Divalent metal transporter 1, DMT-1, Solute carrier family 11 member 2, SLC11A2, DCT1, DMT1, NRAMP2应用: WB反应种属: Human, Mouse, Rat
-
分类: 科研抗体货号: P34368别名: 40S ribosomal protein S2, 40S ribosomal protein S4, Protein LLRep3, RPS2, RPS4应用: WB,IF,FCM反应种属: Human, Mouse, Rat
-
分类: 科研抗体货号: P34349别名: Insulin-like growth factor 2 mRNA-binding protein 1, IGF2 mRNA-binding protein 1, IMP-1, IMP1, Coding region determinant-binding protein, CRD-BP, IGF-II mRNA-binding protein 1, VICKZ family member 1, Zipcode-binding protein 1, ZBP-1, IGF2BP1, CRDBP, VICKZ应用: WB,FCM反应种属: Human, Mouse, Rat
-
分类: 科研抗体货号: P34367别名: DNA-directed RNA polymerases I, II, and III subunit RPABC2, RNA polymerases I, II, and III subunit ABC2, DNA-directed RNA polymerase II subunit F, DNA-directed RNA polymerases I, II, and III 14.4 kDa polypeptide, RPABC14.4, RPB14.4, RPB6 homolog, RPC15, P应用: WB反应种属: Human, Mouse, Rat

鄂公网安备42018502007531号
鄂公网安备42018502007531号

